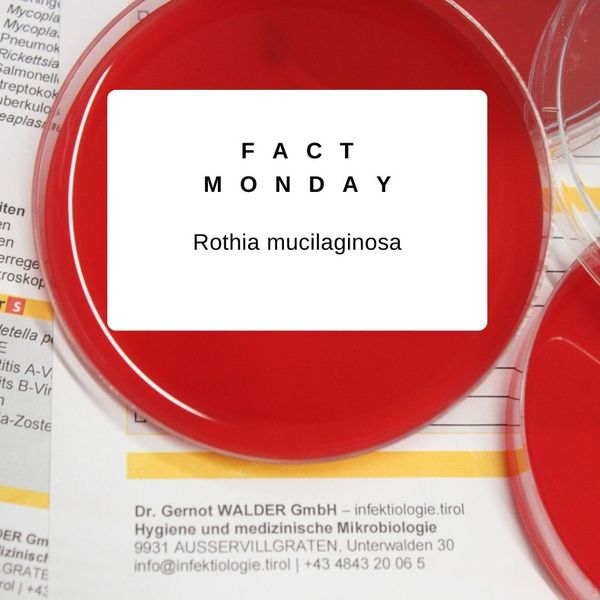

Baustellenupdate…
es geht gut voran

es geht gut voran

Habe ich noch einen ausreichenden Schutz?

#factmonday – Leptospiren

– für Zellkultur & Wasseranalytik

– für die perfekte Mischung
#factmonday – Rothia mucilaginosa

genießt die Zeit! ☀️😊

– Zeckenzeit

#factmonday – Masernvirus